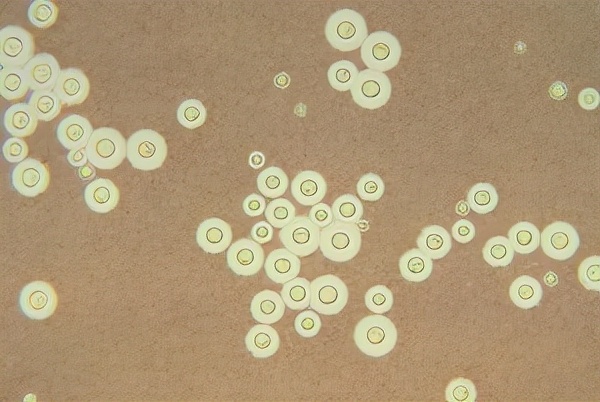
这种病菌1亿年前就有了，后来地球出现人类，它又学会了感染人肺

先看一个奇怪的病例:
这是一位公司职员,中年男性,经常出差,单位体检时发现右肺阴影:

上肺有几个白色小结节,周围有一圈模糊的磨玻璃影,就像光晕一样(晕征)。
因为他没什么症状,也没在意,吃了几天消炎药就没再理会。
结果4个月后,出现咳嗽、痰中带血,回医院复查CT,发现病灶明显增大、增多了:

这就有点懵,咋了?长肺癌了?扩散了?要英年早逝了?吃遍大江南北、游遍五湖四海的理想还没实现呢!不甘心啊!
想法有点多,医生一针给扎好了!
呼吸科医生用一根细长的穿刺针扎入病灶内部,切取一小条组织放到显微镜下观察,没找到癌细胞,放心了,但是找到了一种最近几年逐渐增多的真菌:隐球菌。
隐球菌在地球上存活超过了1亿年,基因不断修正、进化,,还分出了两种跟人类关系密切的杂合体:新生隐球菌杂合体、格特隐球菌杂合体。
在显微镜下给隐球菌拍个正面2寸免冠照片,就长着上图这个样子,多数圆圆的,周围穿了一层厚厚的棉袄(荚膜),这层荚膜会增强它的毒力,还能降低、逃避免疫细胞、抗真菌药物对它的*伤杀**。
实际上,肺隐球菌病除了上面这种肺结节型的表现之外,在CT片上还有两种常见的表现:肺炎型和粟粒性肉芽肿型。
我们下面举例说明,先看肺炎型:

这是一位26岁的姑娘,胸痛半个月,CT发现右肺大片白色实变,周围有少量磨玻璃影,最终确诊肺隐球菌病,经抗真菌治疗后痊愈。
再看粟粒性肉芽肿型:

这是一位20岁的医学生,因昏迷住院,CT发现双肺多发白色斑点,像粟粒一样,这种类型比较少见,跟粟粒型肺结核有点像。
后来发现他体内的隐球菌已经播散,还引起了脑部的隐球菌感染,这是造成他昏迷的原因,这种类型有时候是有生命危险的,还好他后来没事了。

说到这里我们简单总结一下,肺隐球菌病有3种常见的CT表现:
1.结节肿块型,表现为单发或多发的结节或肿块(肉芽肿性炎),边界清晰或者伴有晕征,当伴有晕征时提示意义较大。需要留意:这种类型常常被误诊为肺癌或者肺结核,因为它也常出现毛刺、空洞、支气管截断征等等,我们后面会讲鉴别诊断。
2.肺炎型,也有人称其为浸润实变型,多见于免疫力下降的人群,进展快,表现为磨玻璃影、斑片状实变,可以融合为大片实变,内部可见小空洞,周围还常伴小结节,普通抗生素无效,需要抗真菌治疗;
3.粟粒性肉芽肿型,这种比较少见,进展最快,预后不良。
隐球菌从哪里来?是怎么感染人类的?
这种真菌是从哪里来的?怎样躲避它呢?
隐球菌分很多种类型,能感染人类的主要有两种:新生隐球菌和格特隐球菌。
据统计,人类的隐球菌感染,80%为新生隐球菌(多为免疫力下降的人群),20%为格特隐球菌,它俩长得非常像,但老家却不是一个村的。

图片来自北京世纪坛医院 薛新颖教授
新生隐球菌:最常见于鸽子粪,还有金丝雀,鹦鹉,文鸟、鸡、火鸡等经常出没的地方。
有人就好奇了:这种隐球菌为啥喜欢大粪呢?跟屎壳郎是*亲近**哪?
它俩的血缘关系不好考证,毕竟它们都没有排族谱、春节给长辈拜年的好习惯,不过鸽粪呈酸性、有高浓度尿酸和葡萄糖,非常对新生隐球菌的口味,所以能随着鸟类的全球迁徙而遍布地球各地,随便引起人类的感染。
我们今年遇到的一个病例,就是去湿地公园旅游,没戴口罩,结果回来后感染了肺隐球菌病,花了不少钱(抗真菌药疗程长,常常比较贵,比湿地公园的门票贵好多倍)。

那么另一个问题:鸽子会被自己的大粪传染不?
不会!隐球菌的适宜生长温度是25℃和37℃,而鸽子体温在41-42℃左右,隐球菌不喜欢它们,只喜欢它们的粪便。
当然这充分说明了,隐球菌不是美食家!
当然它们可能是农业肥料专家!并且会随着鸟类粪便污染蔬菜、装饰材料等,造成一些隐源性感染。
接下来说说格特隐球菌,它不喜欢鸽子粪,主要存在于桉树中,就是下图这种:

桉树原生于澳大利亚及其周边地区,但是由于其经济、环境与文化价值,被广泛引种至许多国家和地区。至2008年,全球约有100个国家和地区引种、栽培桉树,我国约有260万公顷,主要分布于华南东南沿海及西南地区。
廖万清教授在2013年首次从我国昆明海埂公园内的一棵粗大的蓝桉的树洞腐生物中分离出格特隐球菌,验证了我国格特隐球菌病人感染源来自国内自然环境的假说(张嵩《肺部真菌感染临床表现与解析》)。
所以,去小树林玩耍的时候,记得戴口罩哦!

下面回答本章节第二个问题:隐球菌怎样感染人类?
隐球菌的感染途径是:通过呼吸道吸入环境适应能力较强的真菌孢子(直径1-2微米)感染人类,隐球菌的孢子和小的干燥酵母细胞(直径1-5微米)可到达下呼吸道和肺泡。还有少部分可以通过消化道、破损的皮肤黏膜感染人类。
面对真菌感染,不必草木皆兵
人类是有免疫屏障保护的,即使吸入真菌也不一定会发病。
吸入人体的隐球菌孢子有3个结局:
1.被清除,这种最常见,;人类气道的黏膜纤毛、黏液性表面活性物质、巨噬细胞等会黏附、清除大多数病原微生物。正常人可在24-48小时内清除90%的真菌病原体
2.感染发病,当吸入菌量较大,或人体免疫力下降时,可以发病;
3.吸入后未被及时清除,也不发病,而是被被肉芽肿包裹潜伏,等待身体免疫力低下时发病。

所以我们就理解了,比如艾滋病患者因为细胞免疫缺陷,更容易感染这类真菌。而血液病、化疗患者戴口罩,可以阻挡很多病菌包括真菌的侵入。
最后讲一下隐球菌病的诊断和治疗
肺真菌感染并不常见,尤其是免疫力正常的人群,所以往往不能只依赖CT影像诊断,病理诊断才是隐球菌病的金标准。
就像本文开篇那位公司职员,从穿刺标本中查到了穿棉衣(荚膜)的隐球菌。
而隐球菌外围的厚厚的荚膜,又为我们提供了另一个阳性率很高、很有价值的检测手段:
隐球菌荚膜多糖抗原检测。

通过外周血、肺泡灌洗液、穿刺活检物的隐球菌荚膜抗原检测,有很高的提示意义,结合肺部CT表现,大多数可以明确诊断。而且这项检测费用也不高,好像是200多块。
不过有个细节大家要了解:病人感染好转后,隐球菌荚膜抗原也会持续阳性,最长的随访一年后查抗原还是阳性,说明这种抗原可以长期存在。这种情况下如果病人再感染别的病原体,荚膜抗原的作用就只能做个参考,故有专家提议对肺隐球菌病建议还是尽量取到病理,查到隐球菌。

中间那个红红的就是隐球菌,周围有环形荚膜
最后就是治疗了,只要查到病原体就不怕了,因为这个有敏感药物可以治愈。
肺隐球菌病治疗有敏感的抗真菌药物,疗程6~12个月。国内专家共识,对免疫功能正常的肺隐球菌病中无症状患者,建议医学观察或口服抗真菌药物,疗程3~6个月。
治疗终点的判断,主要依据临床症状及病变吸收情况,而不必等待乳胶凝集试验转阴。
最后简单重复一个提醒:到陌生场所,比如阴暗潮湿的角落、桉树林、有鸽粪的地方,别忘了戴口罩!

#健康明星计划#
参考文章:
肺部真菌感染临床与影像解析,张嵩;
肺部疑难疾病多学科会诊,路希维、李海潮。